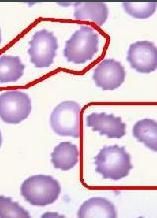
紅細胞增多症

病症概述
紅細胞增多症妊娠合併紅細胞增多症通常是繼發的,與缺氧有關。大多數繼發於先天性心臟病和肺部疾患,如果此病嚴重則不可能妊娠。
紅細胞增多症與妊娠的關係:妊娠並不加重此病,Ruch(1964)描寫其紅細胞容量,在非孕期與孕期水平一樣,均為63,然而在兩個妊娠的每一個時期則紅細胞容量變動範圍很大,一個在妊娠中期其水平可低到35,到足月可增高約44。患此病的婦女胎兒死亡率較高。
Kooffer(1981)報導用放射免疫測定紅細胞生成素,能分辨紅細胞增多症的圖象。此法對繼發性紅細胞增多症評價較高。然而未注意妊娠期的變化。尚應與真性紅細胞增多症相鑑別。
常見種類
真性紅細胞增多症
真性紅細胞增多症(polycythemia vera)是一種由於異常的多能幹細胞克隆增殖所造成的骨髓增生性疾病。發病率約為1/10萬,多發生在60歲左右的老年人,兒童時期極罕見,發生在25歲以下的只占所有病例的1%。
起病大多緩慢。由於紅細胞增多,導致血液粘稠度增加,血流緩慢,微循環障礙,全身血管擴張充血。常見的症狀有頭痛眩暈、視力障礙、面色發紅、眼結膜充血、血壓增高、肝脾腫大和血管栓塞等症狀。亦常見鼻衄和皮膚瘀斑。夜間多汗和體重下降亦為常見現象。眼底檢查可見視網膜靜脈擴張、充血、粗細不等,顏色深紫等。約1/3病人有舒張血壓增高現象。
骨髓細胞染色體檢查可見多種非特異性畸變,如第8三體、第8三體或8和8或22部分缺失等。
紅細胞計數大多在6~10×1012/L(600萬~1000萬/mm3)以上,血紅蛋白160~250g/L(16~25g/dl),紅細胞壓積54%~80%,白細胞中度增高。血小板增多可達400~1100×109/L(40萬~110萬/mm3)。骨髓增生活躍,粒細胞/紅細胞下降。血紅蛋白F輕度增高,白細胞鹼性磷酸酶和血漿B12增高。紅系祖細胞在體外培養不需要紅細胞生成素即可增殖。動脈血氧飽和度>92%。
目前尚無根治方法,一般採用間斷靜脈放血療法,使血容量迅速降至正常,以緩解症狀和減少血栓形成等嚴重併發症。亦可採用馬里蘭、環磷醯胺或羥基尿等,可取得短暫療效。
預後差,多死於靜脈栓塞、大出血、或發展成為骨髓纖維化及急性白血病。
家族性良性紅細
胞增多症
家族性良性紅細胞增多症(Benignfamilial polycythemia)為常染色體遺傳性疾病,有不同的外顯性。比較罕見。 症狀較輕,常有頭痛、嗜睡、眩暈和易疲倦;或完全沒有自覺症狀。病兒面色深紅,眼結膜充血,但多無脾臟腫大。 血象檢查僅有紅細胞系增生過盛,血紅蛋白常在200g/L(20g/dl)以上,血容量增多。白細胞與血小板正常。家族中有同樣病人。此症多呈良性經過,可活到正常年若因血液粘稠而產生症狀,則可採用放血療法。
繼發性紅細胞增多症
繼發性紅細胞增多症(Secondarypoly cythemia)由許多不同的原因引起。各種可引起紅細胞增多症的疾病見下:
繼發性紅細胞增多症的分類:
組織缺氧或氧釋放障礙
生理性:
1)胎兒期2)環境中氧含量不足:高原地區
病理性:
1)肺換氣不足:肺部疾患如支氣管擴張、肺心病、肥胖症(Pickwickian Syndrome)2)肺動脈、靜脈瘺
3)青紫型先天性心臟病
4)異常血紅蛋白病:血紅蛋白M、硫化血紅蛋白和正鐵血紅蛋白帶氧能力差
2.骨髓生成紅細胞的功能增強
內源性:
1)腎性:腎胚組織瘤、腎上腺樣瘤、多囊腎、腎動脈狹窄等2)腎上腺:嗜鉻細胞瘤、Cushing綜合徵、先天性腎上腺增生、腎上腺腺瘤合併原發性醛固酮增多症等
3)肝:肝細胞瘤
4)小腦:成血管細胞瘤
外源性:
1)套用睪丸酮或類似藥物2)套用生長激素
新生兒
(1)經胎盤輸血:母親輸血給胎兒,雙胎中受血者(2)臍帶結紮過晚
繼發性紅細胞增多症主要由於組織缺氧,致紅細胞生成素的分泌代償性增多;或由於發生可以產生紅細胞生成素的良性或惡性腫瘤以及服用促使紅細細胞輸血或臍帶結紮過晚引起。
症狀輕重不等,視原發病而異。除紅細胞增多外,白細胞和血小板多正常。
主要治療原發病。紅細胞增多是一種代償現象,不需要治療。根除原發病後,紅細胞增多現象可以自然痊癒。若紅細胞壓積超過65%,則血液粘稠度極度增加,應間斷地從靜脈放血用等量血漿或生理鹽水換血。
治療方法
紅細胞增多症2、化療:
(1)、羥基脲系一種核糖核酸還原酶,對真性紅細胞增多症有良好抑制作用,且無致白血病副反應,每日劑量為15~20mg/kg。如白細胞維持在3.5~5×109/L,可長期間歇套用羥基脲。
(2)、烷化劑有效率80%~85%。環磷醯胺及左鏇苯胺酸氮芥(馬法侖)作用較快,緩解期則以白消安及苯丁酸氮芥為長,療效可持續半年左右。苯丁酸氮芥副作用較少,不易引起血小板減少,為其優點。烷化劑也有引起白血病但較放射性核素為少。烷化劑的用量和方法:開始劑量環磷醯胺為100~150mg/d,白消安,馬法侖及苯丁酸氮芥為4~6mg/d,緩解後停用4周后可給維持劑量,環磷醯胺為每日50mg,白消安等為每日或隔日2mg。
(3)、三尖杉酯鹼:中國國內報告套用本品2~4mg,加於10%葡萄糖液中靜脈滴注每日一次,連續或間歇套用到血細胞壓積及血紅蛋白降到正常為止。達到緩解時間平均為60d,中數緩解期超過18個月。
3、α干擾素治療:干擾素有抑制細胞增殖作用,近年也已開始用於本病治療,劑量為300萬U/m2,每周3次,皮下注射。治療3個月後脾臟縮小,放血次數減少。緩解率可達80%。
4、放射性核素治療32P的β射線能抑制細胞核分裂,使細胞數降低。初次口服劑量為11.1×107~14.8×107Bq,約6周后紅細胞數開始下降,3~4個月接近正常,症狀有所緩解,約75%~80%有效。如果3個月後病情未緩解,可再給藥一次。緩解時間達2~3年。32P有可能使患者轉化為白血病的危險,故近年已很少套用。預後差,多死於靜脈栓塞、大出血、或發展成為骨髓纖維化及急性白血病。
治療原則
紅細胞增多症轉歸與預後:本病初期,以瘀血及肝熱表現為主,多為實證。但實證血瘀病久後,因瘀血阻滯影響人體氣血陰陽的化生,可漸轉成虛實夾雜之證,虛證的表現有氣虛、血虛、陰虛、陽虛的不同,部分病人氣血陰陽的虧虛可以相兼出現,如氣陰兩虛、氣血兩虛及氣損及陽等。
本病大多病程較長,其病情輕重及預後取決於瘀血的輕重,瘀血阻滯較重,則預後較差;若瘀血阻滯較輕,則預後尚可。如病程中出現面黯唇紫,倦怠乏力,四肢逆冷,心胸劇烈刺痛,脈結或遲的陽虛血瘀表現;或出現語言蹇澀,肢體運動不遂,甚或神志不清等表現均屬危重證候。如因熱迫血行或瘀血阻滯,血不循經而出現突然大量嘔血、便血等症亦為難治之證,預後較差。
調護:應囑患者注意調理情志,保持心情舒暢,忌食辛辣之物,宜進清淡飲食。以防七情抑鬱,七情化火或食郁化火而出現瘀血合併肝火之證加重病情。另應囑病人慎起居,防止感染外邪,郁而化熱,熱入營血或熱入心包、熱鬧清竅使病情轉危。
預防:平素應囑病人起居有節,保持心情舒暢,正確對待疾病,樹立戰勝疾病的信心,否則七情所傷易使病情加重。飲食宜清淡,忌食辛辣助熱之品。病至中晚期,病情多呈虛實夾雜之象,故應防止過勞耗傷正氣,或勞後復感外邪加重病情。